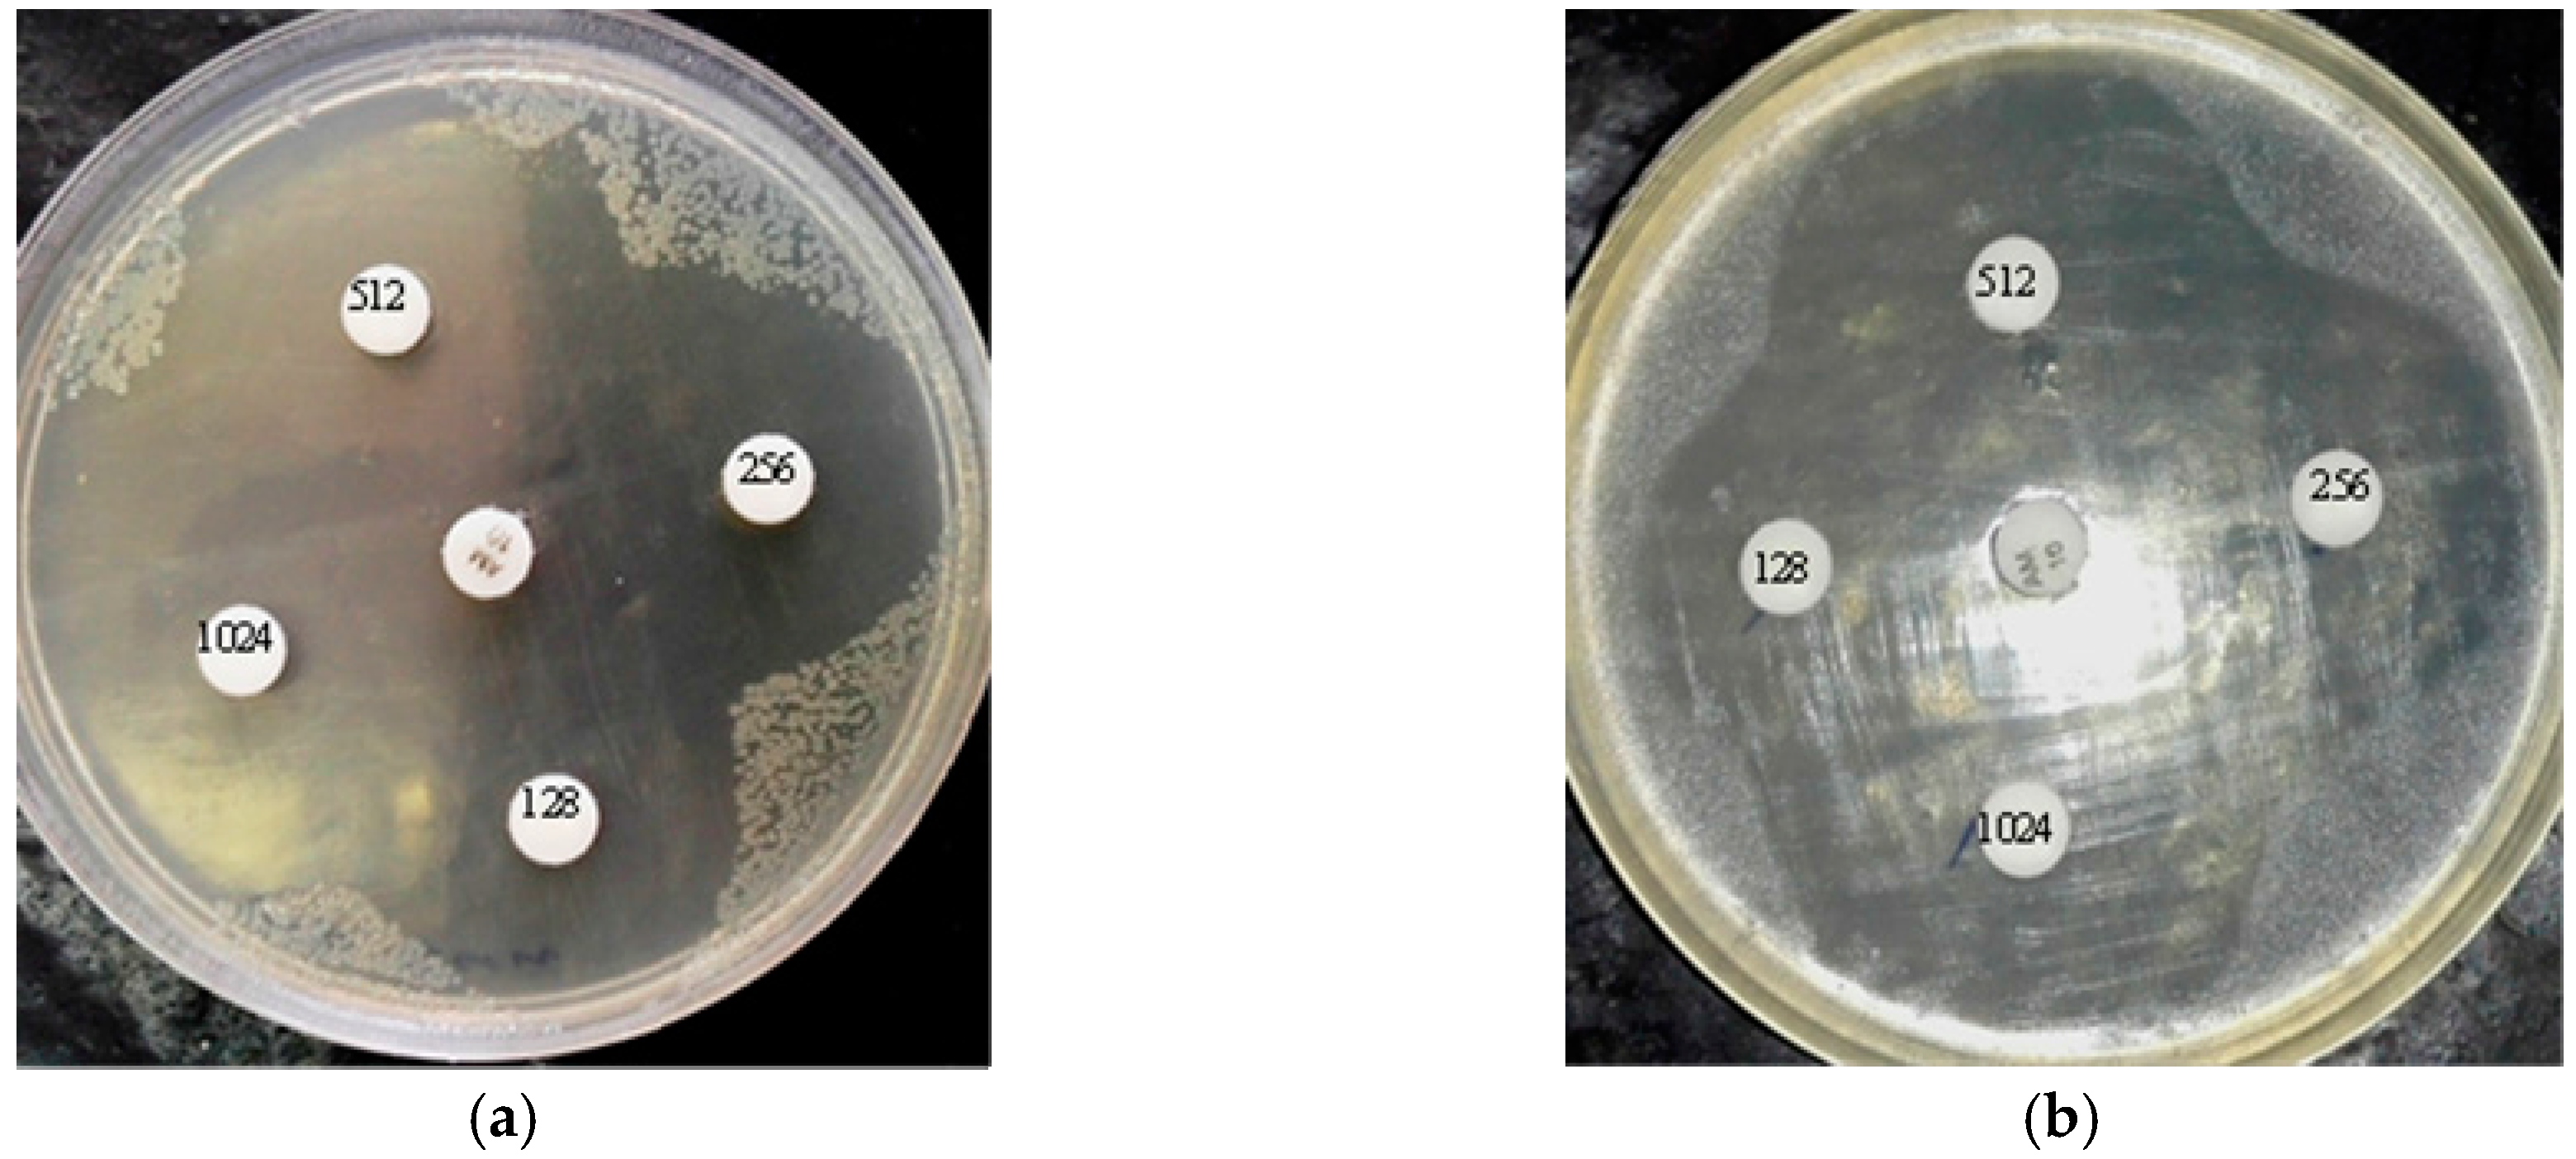
Molecules 22 00822 g002a

Production of Recombinant Antimicrobial Polymeric Protein Beta Casein-E 50-52 and Its Antimicrobial Synergistic Effects Assessment with Thymol
Abstract
:1. Introduction
2. Results
2.1. Expression of BCN E 50-52 in E. coli BL21
2.2. Purification and Refolding of BCN E 50-52
2.3. Antibacterial and Antifungal Activities
2.4. Bactericidal and Fungicidal Activities
2.5. Agar Disk Diffusion
2.6. Time–Kill Curves
2.7. Growth Kinetic Curves
2.8. SEM Microscopy
3. Discussion
4. Materials and Methods
4.1. Materials and Chemicals
4.2. Bacterial Strains
4.3. Construction of the Expression Vector pET21a-BCN E 50-52
4.4. Expression of BCN E 50-52 in E. coli BL21
4.5. Purification of BCN E 50-52
4.6. Refolding Optimization of BCN E 50-52
4.7. Concentration of BCN E 50-52
4.8. Preparation of Standardized Inoculum
4.9. Preparation of the Thymol Solution
4.10. Determination of Antibacterial Minimum Inhibitory Concentration (MIC)
4.11. Determination of Minimum Bactericidal Concentration (MBC)
4.12. Determination of Antifungal MIC
4.13. Determination of Minimum Fungicidal Concentration (MFC)
4.14. Agar Disk Diffusion
4.15. Synergy Study
4.16. Time–Kill Curves
4.17. Growth Curve
4.18. SEM Microscopy
4.19. Statistical Analysis
Acknowledgments
Author Contributions
Conflicts of Interest
References
- Rai, M.; Pandit, R.; Gaikwad, S.; Kövics, G. Antimicrobial peptides as natural bio-preservative to enhance the shelf-life of food. J. Food Sci. Technol. 2016, 53, 3381–3394. [Google Scholar] [CrossRef] [PubMed]
- Sung, S.Y.; Sin, L.T.; Tee, T.T.; Bee, S.T.; Rahmatb, A.R.; Rahmanb, W.A.W.A.; Tana, A.-C.; Vikhraman, M. Antimicrobial agents for food packaging applications. Trends Food Sci. Technol. 2013, 33, 110–123. [Google Scholar] [CrossRef]
- Gautam, N.; Sharma, N. Bacteriocin: Safest approach to preserve food products. Indian J. Microbiol. 2009, 49, 204–211. [Google Scholar] [CrossRef] [PubMed]
- Cui, Y.; Zhang, C.; Wang, Y.; Shi, J.; Zhang, L.; Ding, Z.; Qu, X.; Cui, H. Class IIa bacteriocins: Diversity and new developments. Int. J. Mol. Sci. 2012, 13, 16668–166707. [Google Scholar] [CrossRef] [PubMed]
- Svetoch, E.A.; Eruslanov, B.V.; Perelygin, V.V.; Mitsevich, E.V.; Mitsevich, I.P.; Borzenkov, V.N.; Levchuk, V.P.; Svetoch, O.E.; Kovalev, Y.N.; Stepanshin, Y.G.; et al. Diverse antimicrobial killing by Enterococcus faecium E 50-52. bacteriocin. J. Agric. Food Chem. 2008, 56, 1942–1948. [Google Scholar] [CrossRef] [PubMed]
- Svetoch, E.A.; Eruslanov, B.V.; Kovalev, Y.N.; Mitsevich, E.V.; Mitsevich, I.P.; Levchuk, V.P.; Fursova, N.K.; Perelygin, V.V.; Stepanshin, Y.G.; Teymurasov, M.G.; et al. Antimicrobial Activities of Bacteriocins E 50-52 and B 602 Against Antibiotic-Resistant Strains Involved in Nosocomial Infections. Probiotics Antimicrob. Proteins 2009, 1. [Google Scholar] [CrossRef] [PubMed]
- Klint, J.K.; Senff, S.; Saez, N.J.; Seshadri, R.; Lau, H.Y.; Bende, N.S.; Undheim, E.A.; Rash, L.D.; Mobli, M.; King, G.F. Production of Recombinant Disulfide-Rich Venom Peptides for Structural and Functional Analysis via Expression in the Periplasm of E. coli. PLoS ONE 2013. [Google Scholar] [CrossRef] [PubMed]
- Pane, K.; Durante, L.; Pizzo, E.; Varcamonti, M. Rational Design of a Carrier Protein for the Production of Recombinant Toxic Peptides in Escherichia coli. PLoS ONE 2016, 11. [Google Scholar] [CrossRef] [PubMed]
- Audic, J.L.; Chaufer, B.; Daufin, G. Non-food applications of milk components and dairy co-products: A review. Le Lait 2003, 83, 417–438. [Google Scholar] [CrossRef]
- Shapira, A.; Assaraf, Y.G.; Epstein, D.; Livney, Y.D. Beta-casein Nanoparticles as an Oral Delivery System for Chemotherapeutic Drugs: Impact of Drug Structure and Properties on Co-assembly. Pharm. Res. 2010, 27, 2175–2186. [Google Scholar] [CrossRef] [PubMed]
- Esmaili, M.; Ghaffari, S.M.; Moosavi-Movahedi, Z.; Atri, M.; Sharifizadeh, A.; Farhadi, M.; Yousefi, R.; Chobert, J.M.; Haertlé, T.; Moosavi-Movahedi, A.A. Beta casein-micelle as a nano vehicle for solubility enhancement of curcumin; food industry application. LWT Food Sci. Technol. 2011, 44, 2166–2172. [Google Scholar] [CrossRef]
- Follows, D.; Holt, C.; Nylander, T.; Thomas, R.K.; Tiberg, F. Beta-casein adsorption at the silicon oxide-aqueous solution interface: Calcium ion effects. Biomacromolecules 2004, 5, 319–325. [Google Scholar] [CrossRef] [PubMed]
- Olof, S.; Anil, K.S.; Marie, S. Adsorption of β-casein to hydrophilic silica surfaces. Effect of pH and electrolyte. Food Hydrocoll. 2014, 36, 332–338. [Google Scholar]
- Szyk-Warszyńska, L.; Kilan, K.; Socha, R.P. Characterization of casein and poly-l-arginine multilayer films. J. Colloid Interface Sci. 2014, 423, 76–84. [Google Scholar] [CrossRef] [PubMed]
- Valencia-Chamorro, S.A.; Palou, L.; Del Río, M.A.; Pérez-Gago, M.B. Antimicrobial edible films and coatings for fresh and minimally processed fruits and vegetables: A review. Crit. Rev. Food Sci. Nutr. 2011, 51, 872–900. [Google Scholar] [CrossRef] [PubMed]
- Damodaran, S.; Sengupta, T. Dynamics of competitive adsorption of alphas-casein and beta-casein at planar triolein-water interface: Evidence for incompatibility of mixing in the interfacial film. J. Agric. Food Chem. 2003, 51, 1658–1665. [Google Scholar] [CrossRef] [PubMed]
- Flórez-Castillo, J.M.; Perullini, M.; Jobbágy, M.; Cano, H. Enhancing Antibacterial Activity against Escherichia coli K-12 of Peptide Ib-AMP4 with Synthetic Analogues. Int. J. Pept. Res. Ther. 2014, 20, 365–369. [Google Scholar] [CrossRef]
- Wang, Q.; Fu, W.; Ma, Q; Yu, Z.; Zhang, R. Production of bacteriocin E 50-52 by small ubiquitin-related modifier fusion in Escherichia coli. Pol. J. Microbiol. 2013, 62, 345–350. [Google Scholar] [PubMed]
- Jiang, Z.; Vasil, A.I.; Hale, J.D.; Hancock, R.E.; Vasil, M.L.; Hodges, R.S. Effects of net charge and the number of positively charged residues on the biological activity of amphipathic α-helical cationic antimicrobial peptides. Biopolymers 2008, 90, 369–383. [Google Scholar] [CrossRef] [PubMed]
- Zhao, X.; Shi, C.; Meng, R.; Liu, Z.; Huang, Y.; Zhao, Z.; Guo, N. Effect of nisin and perilla oil combination against Listeria monocytogenes and Staphylococcus aureus in milk. J. Food Sci. Technol. 2016, 53, 2644–2653. [Google Scholar] [CrossRef] [PubMed]
- Ramos, M.; Beltrán, A.; Peltzer, M.; Valente, A.J.M.; Garrigós, M.C. Release and antioxidant activity of carvacrol and thymol from polypropylene active packaging films. LWT-Food Sci. Technol. 2014, 58, 470–477. [Google Scholar] [CrossRef]
- Trombetta, D.; Castelli, F.; Sarpietro, M.G.; Venuti, V.; Cristani, M.; Daniele, C.; Saija, A.; Mazzanti, G.; Bisignano, G. Mechanisms of Antibacterial Action of Three Monoterpenes. Antimicrob. Agents Chemother. 2005, 49, 2474–2478. [Google Scholar] [CrossRef] [PubMed]
- Froger, A.; Hall, J.E. Transformation of Plasmid DNA into E. coli Using the Heat Shock Method. J. Vis. Exp. 2007, 6. [Google Scholar] [CrossRef] [PubMed]
- Farhangnia, L.; Ghaznavirad, E.; Mollaee, N.; Abtahi, H. Cloning, Expression, and Purification of Recombinant Lysostaphin from Staphylococcus simulans. Jundishapur J. Microbiol. 2014, 7. [Google Scholar] [CrossRef] [PubMed]
- Sivashanmugam, A.; Murray, V.; Cui, C.; Zhang, Y.; Wang, J.; Li, Q. Practical protocols for production of very high yields of recombinant proteins using Escherichia coli. Protein Sci. 2009, 185, 936–948. [Google Scholar] [CrossRef] [PubMed]
- Molaee, N.; Abtahi, H.; Mosayebi, G. Expression of Recombinant Streptokinase from Streptococcus P yogenes and Its Reaction with Infected Human and Murine Sera. Iran J. Basic Med. Sci. 2013, 16, 985–989. [Google Scholar] [PubMed]
- Yamaguchi, H.; Miyazaki, M. Refolding Techniques for Recovering Biologically Active Recombinant Proteins from Inclusion Bodies. Biomolecules 2014, 4, 235–251. [Google Scholar] [CrossRef] [PubMed]
- Choi, H.; Chakraborty, S.; Liu, R.; Gellman, S.H.; Weisshaar, J.C. Medium Effects on Minimum Inhibitory Concentrations of Nylon-3 Polymers against E. coli. PLoS ONE 2014, 9. [Google Scholar] [CrossRef] [PubMed]
- Qiu, J.; Wang, D.; Xiang, H.; Feng, H.; Jiang, Y.; Xia, L.; Dong, J.; Lu, J.; Yu, L.; Deng, X. Subinhibitory concentrations of thymol reduce enterotoxins A and B and α-hemolysin production in Staphylococcus aureus isolates. PLoS ONE 2010, 5. [Google Scholar] [CrossRef] [PubMed]
- CLSI Document M07-A10. Methods for Dilution Antimicrobial Susceptibility Tests for Bacteria that Grow Aerobically; Clinical and Laboratory Standards Institute: Wayne, PA, USA, 2015. [Google Scholar]
- Elshikh, M.; Ahmed, S.; Funston, S.; Dunlop, P.; McGaw, M.; Marchant, R.; Banat, I.M. Resazurin-based 96-well plate microdilution method for the determination of minimum inhibitory concentration of biosurfactants. Biotechnol. Lett. 2016, 38, 1015–1019. [Google Scholar] [CrossRef] [PubMed]
- CLSI Document M27-S4. Method for Broth Dilution Antifungal Susceptibility Testing of Yeasts; Fourth Informational Supplement; Clinical and Laboratory Standards Institute: Wayne, PA, USA, 2012. [Google Scholar]
- CLSI Document M38-A2. Reference Method for Broth Dilution Antifungal Susceptibility Testing of Filamentous Fungi, Approved Standard, 2nd Ed. ed; Clinical and Laboratory Standards Institute: Wayne, PA, USA, 2008. [Google Scholar]
- Jang, W.S.; Kim, H.K.; Lee, K.Y.; Kim, S.A.; Han, Y.S.; Lee, I.H. Antifungal activity of synthetic peptide derived from halocidin, antimicrobial peptide from the tunicate, Halocynthia aurantium. FEBS Lett. 2006, 580, 1490–1496. [Google Scholar] [CrossRef] [PubMed]
- Mania, D.; Hilpert, K.; Ruden, S.; Fischer, R.; Takeshita, N. Screening for antifungal peptides and their modes of action in Aspergillus nidulans. Appl. Environ. Microbiol. 2016, 76, 7102–7108. [Google Scholar] [CrossRef] [PubMed]
- De Castro, R.D.; de Souza, T.M.; Bezerra, L.M.; Ferreira, G.L.; Costa, E.M.; Cavalcanti, A.L. Antifungal activity and mode of action of thymol and its synergism with nystatin against Candida species involved with infections in the oral cavity: An in vitro study. BMC Complement. Altern. Med. 2015, 15. [Google Scholar] [CrossRef] [PubMed]
- CLSI Document M100-S25. Performance Standards for Antimicrobial Susceptibility Testing; Twenty-First Informational Supplement; Clinical and Laboratory Standards Institute: Wayne, PA, USA, 2008. [Google Scholar]
- Iqbal, J.; Siddiqui, R.; Kazmi, S.U.; Khan, N.A. A Simple Assay to Screen Antimicrobial Compounds Potentiating the Activity of Current Antibiotics. Biomed. Res. Int. 2013, 2013. [Google Scholar] [CrossRef] [PubMed]
- Seesom, W.; Jaratrungtawee, A.; Suksamrarn, S.; Mekseepralard, C.; Ratananukul, P.; Sukhumsirichart, W. Antileptospiral activity of xanthones from Garcinia mangostana and synergy of gamma-mangostin with penicillin G. BMC Complement. Altern. Med. 2013, 13, 182–188. [Google Scholar] [CrossRef] [PubMed]
- Cha, J.D.; Lee, J.H.; Cho, K.M.; Choi, S.M.; Park, J.H. Synergistic Effect between Cryptotanshinone and Antibiotics against Clinic Methicillin and Vancomycin-Resistant Staphylococcus aureus. Evid. Based Complement. Alternat. Med. 2014, 2014, 450572–450588. [Google Scholar] [CrossRef] [PubMed]
- Lora-Tamayo, J.; Murillo, O.; Bergen, P.J.; Nation, R.L.; Poudyal, A.; Luo, X.; Yu, H.Y.; Ariza, J.; Li, J. Activity of colistin combined with doripenem at clinically relevant concentrations against multidrug-resistant Pseudomonas aeruginosa in an in vitro dynamic biofilm model. J. Antimicrob. Chemother. 2014, 69, 2434–2442. [Google Scholar] [CrossRef] [PubMed]
- Ghrairi, T.; Hani, K. Enhanced bactericidal effect of enterocin A in combination with thyme essential oils against L. monocytogenes and E. coli O157:H7. J. Food Sci. Technol. 2013, 52, 2148–2156. [Google Scholar] [CrossRef] [PubMed]
- Mohan, K.V.; Rao, S.S.; Gao, Y.; Atreya, C.D. Enhanced antimicrobial activity of peptide-cocktails against common bacterial contaminants of ex vivo stored platelets. Clin. Microbiol. Infect. 2014, 20, 39–46. [Google Scholar] [CrossRef] [PubMed]
- Rudilla, H.; Fusté, E.; Cajal, Y.; Rabanal, F.; Vinuesa, T.; Viñas, M. Synergistic Antipseudomonal Effects of Synthetic Peptide AMP38 and Carbapenems. Molecules 2016, 21. [Google Scholar] [CrossRef] [PubMed]
- Burt, S.A.; Reinders, R.D. Antibacterial activity of selected plant essential oils against Escherichia coli O157:H7. Lett. Appl. Microbiol. 2003, 36, 162–167. [Google Scholar] [CrossRef] [PubMed]
- Zengin, H.; Baysal, A.H. Antibacterial and Antioxidant Activity of Essential Oil Terpenes against Pathogenic and Spoilage-Forming Bacteria and Cell Structure-Activity Relationships Evaluated by SEM Microscopy. Molecules 2014, 19, 17773–17798. [Google Scholar] [CrossRef] [PubMed]
Sample Availability: Samples of the compounds are available from the authors. |

| Microorganism | MIC (μg/mL) | |||||||
|---|---|---|---|---|---|---|---|---|
| (BCN-E 50-52)A | (BCN-E 50-52)C | FICA | ThymolB | Thymolc | FICB | FICC | Interpretation | |
| Gram-negative | ||||||||
| E. coli | 25 | 8 | 0.031 | 128 | 16 | 0.125 | 0.156 | synergistic |
| S. typhimurium | 256 | 4 | 0.015 | 128 | 32 | 0.25 | 0.265 | synergistic |
| Gram-positive | ||||||||
| S. aureus | 256 | 2 | 0.0078 | 128 | 16 | 0.125 | 0.132 | synergistic |
| L. monocytogenes | 256 | 2 | 0.0078 | 128 | 64 | 0.5 | 0.507 | partial synergy |
| Fungi | ||||||||
| C. albicans | 256 | 8 | 0.031 | 64 | 32 | 0.5 | 0.515 | partial synergy |
| A. flavus | - | - | - | 128 | 64 | 0.5 | - | non-synergistic |
| Microorganism | Separated Studies | |||||
|---|---|---|---|---|---|---|
| (BCN E 50-52)A | Interpretation | ThymolB | Interpretation | |||
| MBC | MBC/MIC | MBC | MBC/MIC | |||
| Gram-negative | ||||||
| E. coli | >512 | 4 | bacteriostatic | 512 | 4 | bacteriostatic |
| S. typhimurium | >512 | >4 | bacteriostatic | >512 | >4 | bacteriostatic |
| Gram-positive | ||||||
| S. aureus | >512 | 8 | bacteriostatic | 512 | 4 | bacteriostatic |
| L. monocytogenes | >512 | >4 | bacteriostatic | 512 | 4 | bacteriostatic |
| Fungi | ||||||
| MFC | MFC/MIC | MFC | MFC/MIC | |||
| C. albicans | >512 | >4 | fungistatic | 256 | 4 | fungistatic |
| A. flavus | - | - | No effects | 256 | 4 | fungistatic |
| Microorganism | Synergism Study | |||||
|---|---|---|---|---|---|---|
| (BCN E 50-52)c | Interpretation | Thymolc | Interpretation | |||
| MBC | MBC/MIC | MBC | MBC/MIC | |||
| Gram-negative | ||||||
| E. coli | 128 | 16 | bacteriostatic | 128 | 8 | bactericidal |
| S. typhimurium | 128 | 64 | bacteriostatic | 128 | 4 | bacteriostatic |
| Gram-positive | ||||||
| S. aureus | 16 | 64 | bacteriostatic | 128 | 4 | bacteriostatic |
| L. monocytogenes | 128 | 64 | bacteriostatic | 256 | 8 | bacteriostatic |
| Fungi | ||||||
| MFC/MIC | MFC/MIC | |||||
| C. albicans | 256 | 32 | fungistatic | 256 | 16 | fungistatic |
| A. flavus | - | - | - | 256 | 4 | fungistatic |
| Organism | FBC | Interpretation | ||
|---|---|---|---|---|
| BCN E 50-52c | ThymolC | FBCI | ||
| Gram-negative | ||||
| E. coli | <0.25 | 0.25 | <0.5 | partial synergy |
| S. typhimurium | <0.25 | < 0.25 | <0.5 | partial synergy |
| Gram-positive | ||||
| S. aureus | <0.25 | 0.25 | <0.5 | partial synergy |
| L. monocytogenes | <0.25 | 0.5 | <0.75 | partial synergy |
| Fungi | ||||
| C. albicans | <0.5 | 1 | <1.5 | no synergy |
| A. flavus | - | 1 | - | no synergy |
© 2017 by the authors. Licensee MDPI, Basel, Switzerland. This article is an open access article distributed under the terms and conditions of the Creative Commons Attribution (CC BY) license (http://creativecommons.org/licenses/by/4.0/).
Share and Cite
Fahimirad, S.; Abtahi, H.; Razavi, S.H.; Alizadeh, H.; Ghorbanpour, M. Production of Recombinant Antimicrobial Polymeric Protein Beta Casein-E 50-52 and Its Antimicrobial Synergistic Effects Assessment with Thymol. Molecules 2017, 22, 822. https://doi.org/10.3390/molecules22060822
Fahimirad S, Abtahi H, Razavi SH, Alizadeh H, Ghorbanpour M. Production of Recombinant Antimicrobial Polymeric Protein Beta Casein-E 50-52 and Its Antimicrobial Synergistic Effects Assessment with Thymol. Molecules. 2017; 22(6):822. https://doi.org/10.3390/molecules22060822
Chicago/Turabian StyleFahimirad, Shohreh, Hamid Abtahi, Seyed Hadi Razavi, Houshang Alizadeh, and Mansour Ghorbanpour. 2017. "Production of Recombinant Antimicrobial Polymeric Protein Beta Casein-E 50-52 and Its Antimicrobial Synergistic Effects Assessment with Thymol" Molecules 22, no. 6: 822. https://doi.org/10.3390/molecules22060822
APA StyleFahimirad, S., Abtahi, H., Razavi, S. H., Alizadeh, H., & Ghorbanpour, M. (2017). Production of Recombinant Antimicrobial Polymeric Protein Beta Casein-E 50-52 and Its Antimicrobial Synergistic Effects Assessment with Thymol. Molecules, 22(6), 822. https://doi.org/10.3390/molecules22060822





